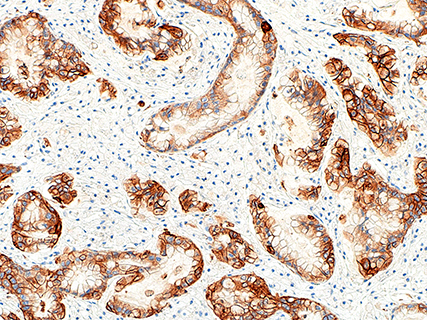

実験動物における異常所見の病理学的解析は、原因追求には必要不可欠な検査であり、とくに感染症の確定診断には、原因となる病原体の検索・同定は微生物検査とともに組織内での病原体の証明が重要となります。また感染症以外に、自然発症腫瘍、炎症および異種細胞(ヒト細胞など)の病理学的診断も行っています。病理標本作製は、H&E染色をはじめ各種特殊染色および免疫染色による対応も可能となっています。免疫染色は、自動免疫染色装置(Bond-Max)を使用し、自動化を行っています。
【業務内容】
病理標本作製


染色

病理診断



PAGE TOP